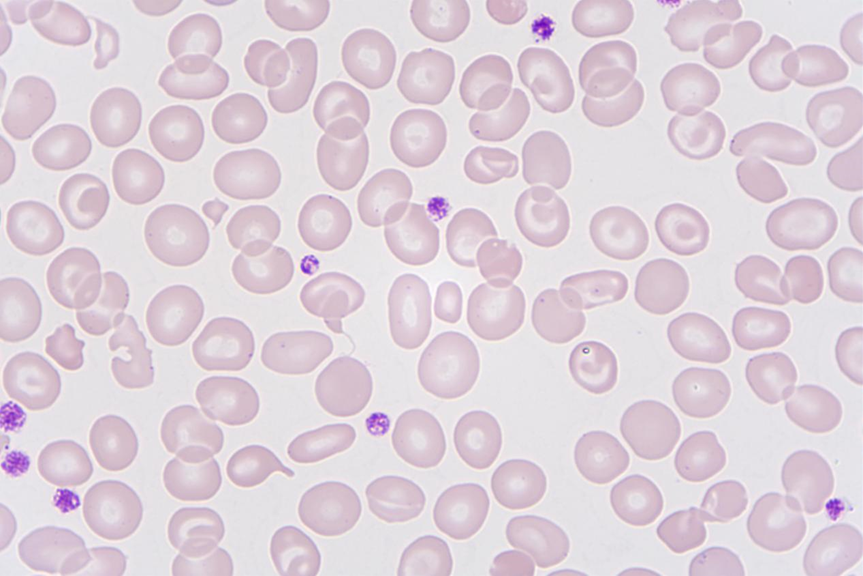
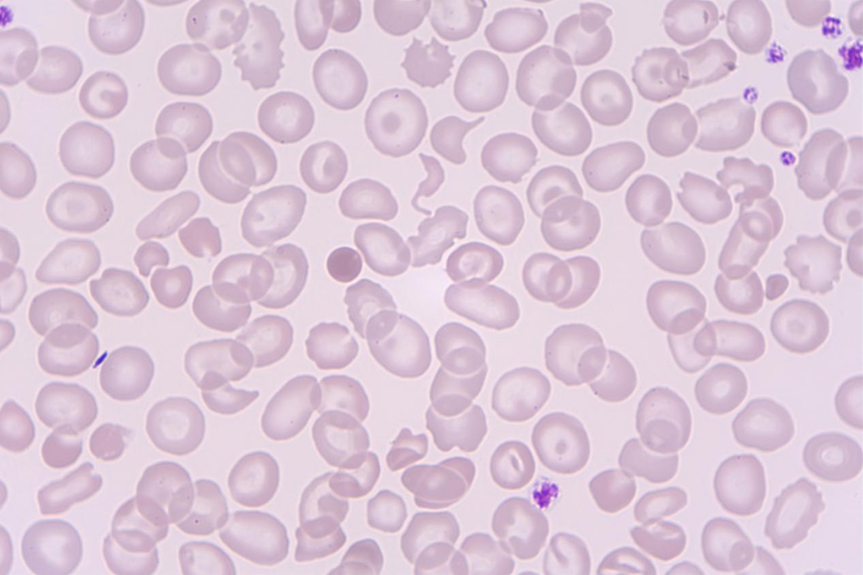
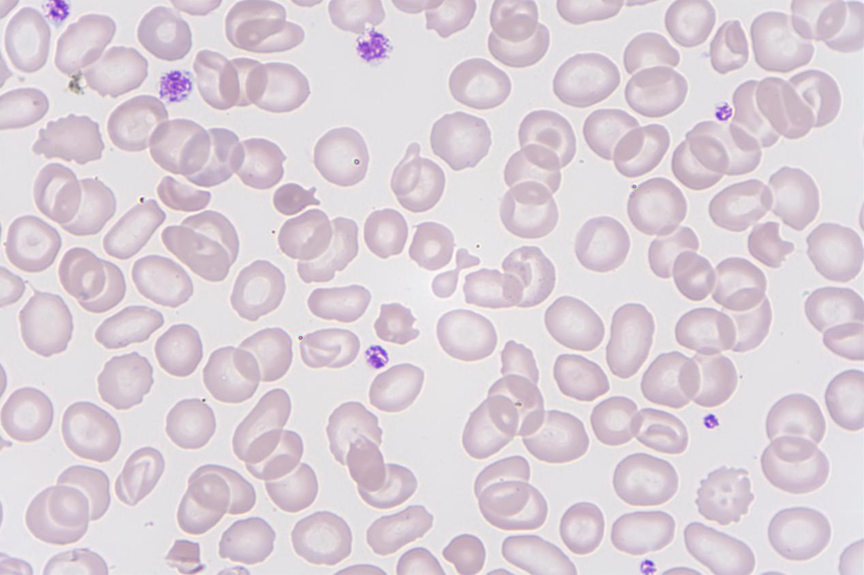
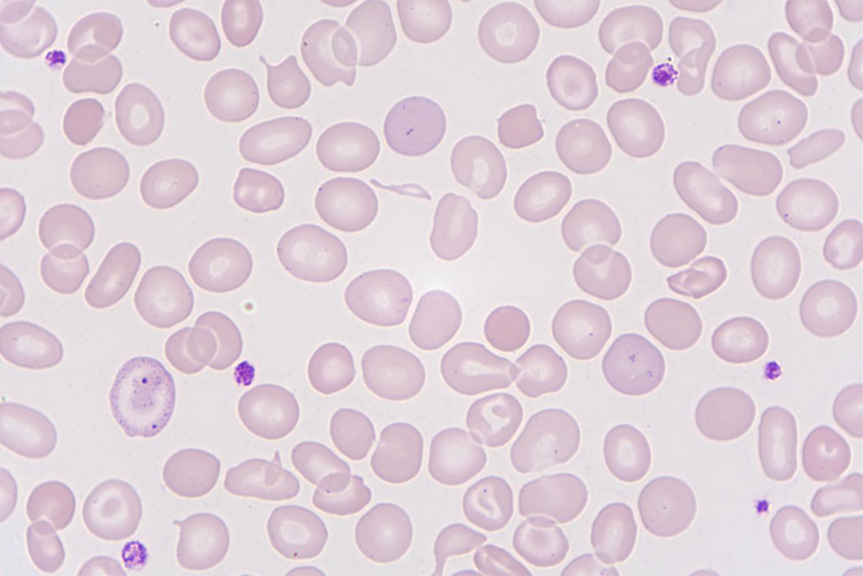

作者:王喆诤 王清泰 刘莉
单位:福建省第二人民医院
前言
贫血是全身循环血液中红细胞总容量减少至正常值以下。全身循环血液中红细胞总容量测定操作技术复杂、重复性差,而血红蛋白浓度、红细胞计数及血细胞比容在绝大多数情况下都能正确反映循环血液红细胞容量的减少,故临床上凡是循环血液单位体积中血细胞比容,血红蛋白浓度和(或)红细胞计数低于正常值即称贫血[1]。贫血的发生是由各种各样的原因致使红细胞生成减少、丢失或破坏过多,并超过骨髓代偿或再生功能的结果。贫血是十分常见的临床症候,许多学科的疾病都可以发生贫血,常有相同的临床和实验室所见,故被认为是一个临床综合征[2]。
依据红细胞形态学指标(MCV、MCH、MCHC)将贫血分为:①大细胞性贫血②正细胞性贫血③小细胞性贫血。当红细胞平均体积(MCV)小于80f1、红细胞平均血红蛋白(MCH)小于28pg和红细胞平均血红蛋白浓度(MCHC)小于 32% 即可诊断为小细胞低色素性贫血[3]。
案例经过
在血常规岗位审核标本时发现一例血小板四项参数均不出结果的标本,查看散点图和仪器报警提示,如图1。

图1
WBC:4.78×109/L,HB:96g/L,PLT:216×109/L,MCV:65.2fl,MCH:18.1pg,血小板直方图尾部抬高,红细胞报警有小红细胞(Microcytosis),为了避免小红细胞干扰血小板计数,加做血小板光学通道PLT-F,如图2。

图2
血常规显示小细胞低色素性贫血,临床上常见的小细胞性贫血主要有慢性病贫血(ACD)、缺铁性贫血(IDA)、地中海贫血(Thal)。这例标本是什么原因呢?查看患者信息,男,65岁,健康查体,先不考虑慢性病贫血,再计算一下Mentzer指数,即MCV除以RBC,若结果<13考虑为珠蛋白生成障碍性贫血(地贫),结果>13考虑为缺铁性贫血。此患者的Mentzer指数为65.2÷5.29≈12.3,地贫的可能性大。推片镜检,如图3-7
图3
图4
图5

图6
图7
镜检可见红细胞大小不等、小红细胞、微小红细胞、靶形红细胞、泪滴形红细胞、鱼形红细胞,部分视野可见红细胞中心淡然区扩大、嗜碱性点彩红细胞、卡波环、帕彭海姆氏小体,基本满足地贫血片特点:血红蛋白少,红细胞大小不等,红细胞中心浅染区扩大,靶形红细胞多,泪滴形红细胞多,微小红细胞多。
接着查看该患者糖化血红蛋白结果,如下图8

图8
仪器提示Suspect Hemoglobinopathy(怀疑血红蛋白病),HbF>5%(9.22%),HbA1C的结果不可信。咨询工程师可知血红蛋白F定量可以诊断重型或中间型β-地贫,中间型β-地贫血红蛋白分析参考范围为:HbF>3.5% HbA2>4.0%。遗憾的是实验室糖化仪不能检测HbA2。
综合以上结果在备注栏里写上小细胞低色素贫血,地中海贫血可能?提示临床医生做进一步检查。
总结
地中海贫血的最终诊断还是需要HPLC、血红蛋白H染色或分子生物学检查,形态学只能起到提示作用。HbF、HbA2联合检测在成人β-地中海贫血筛查中应用,可较好将β-地中海贫血检出,及时发现高危人群,有较高的价值,值得推广[4]。在日常血常规的复检中我们常常会忽视了血小板、红细胞相关参数的改变,实则小小的参数里藏着大大的秘密,血常规看似简单,其实相当考验专业人员的综合能力,散点图、直方图、仪器报警都能从中看出异常的端倪,所以我们一定得认真、细心,不漏掉挽救生命的线索。
参考文献
[1] 张之南等主编. 血液病学 上 [M]. 北京:人民卫生出版社, 2011.
[2] 卢兴国主编;叶向军等副主编;董敖等编著. 贫血诊断学 [M]. 北京:人民卫生出版社, 2015.
[3] 李娟,王荷花主编. 血液病简明鉴别诊断学 [M]. 北京:人民卫生出版社, 2016.
[4] 刘春玲. HbA2和HbF联合检测在成人β-地中海贫血筛查中的价值分析 [J]. 当代医学, 2020, 26(08): 161-2.
编辑—阿毛